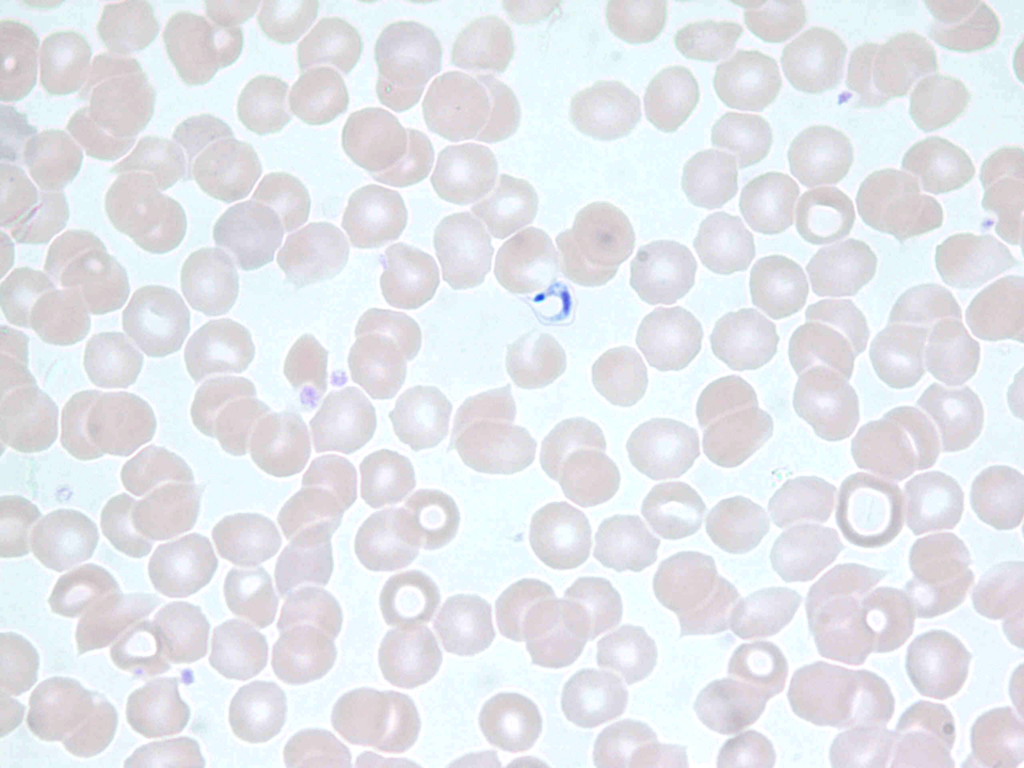

Durante 2025, se notificaron 1.915 casos de enfermedad de Chagas en el país, lo que equivale a una tasa de 0,9 por cada 100.000 habitantes, según cifras del Ministerio de Salud. Estos datos se dan a conocer en el contexto del Día Mundial de la Enfermedad de Chagas, que se conmemora este 14 de abril.
Bajo el lema “Las mujeres en el corazón de la atención: protegiendo a la próxima generación de la enfermedad de Chagas”, la conmemoración de este año pone el foco en la prevención de la transmisión materno-infantil, así como en el acceso oportuno al diagnóstico y tratamiento.
En este contexto, las mujeres embarazadas constituyen un grupo prioritario. Desde 2023, la cobertura de estudio en este grupo alcanza el 90%; sin embargo, solo el 22,4% ha accedido a tratamiento, lo que sigue representando uno de los principales desafíos sanitarios. Ante esta brecha, se están impulsando estrategias para ampliar la cobertura terapéutica y reducir la transmisión.
En esta línea, el Ministerio de Salud junto al Instituto de Salud Pública actualizaron hace un año el algoritmo de diagnóstico para el estudio de hijos e hijas de madres con infección confirmada. Esta medida busca optimizar los tiempos de detección y mejorar el uso de recursos para identificar casos en etapas tempranas.
“Lo relevante de este nuevo algoritmo es que, si son tratados de manera oportuna, tienen la posibilidad de eliminar la presencia del parásito y así disminuir el número de nuevos casos en el país”, señaló María Isabel Jercic, jefa de la sección de Parasitología del ISP.
La enfermedad de Chagas es una infección causada por el parásito Trypanosoma cruzi, transmitido principalmente por insectos triatominos, presentes en zonas de América Latina, incluyendo el norte de Chile. Estos insectos suelen habitar en viviendas con estructuras de barro y se alimentan durante la noche, facilitando la transmisión del parásito.
Tripomastigote metacíclico de Trypanosoma cruzi tinción Giemsa aumento 100 X.
A pesar de los casos registrados, Chile ha logrado importantes avances en el control de la enfermedad. El país certificó la interrupción de la transmisión vectorial, recertificada por la Organización Panamericana de la Salud (OPS) en 2016, y el control de la transmisión por transfusión sanguínea en 2008. En este proceso, el ISP cumple un rol como laboratorio de referencia supranacional para fortalecer las estrategias de eliminación en la región.
En cuanto a los síntomas, la mayoría de los recién nacidos infectados —hijos de madres con Chagas— no presentan manifestaciones clínicas en la fase aguda. No obstante, un pequeño porcentaje puede presentar bajo peso, prematuridad, fiebre, ictericia, aumento del tamaño del hígado y bazo, o dificultad respiratoria. Estos casos requieren diagnóstico mediante pruebas de laboratorio en las primeras semanas de vida.
El tratamiento durante el primer año suele ser altamente efectivo si se inicia de manera oportuna, utilizando medicamentos disponibles en el país como Benznidazol y Nifurtimox.